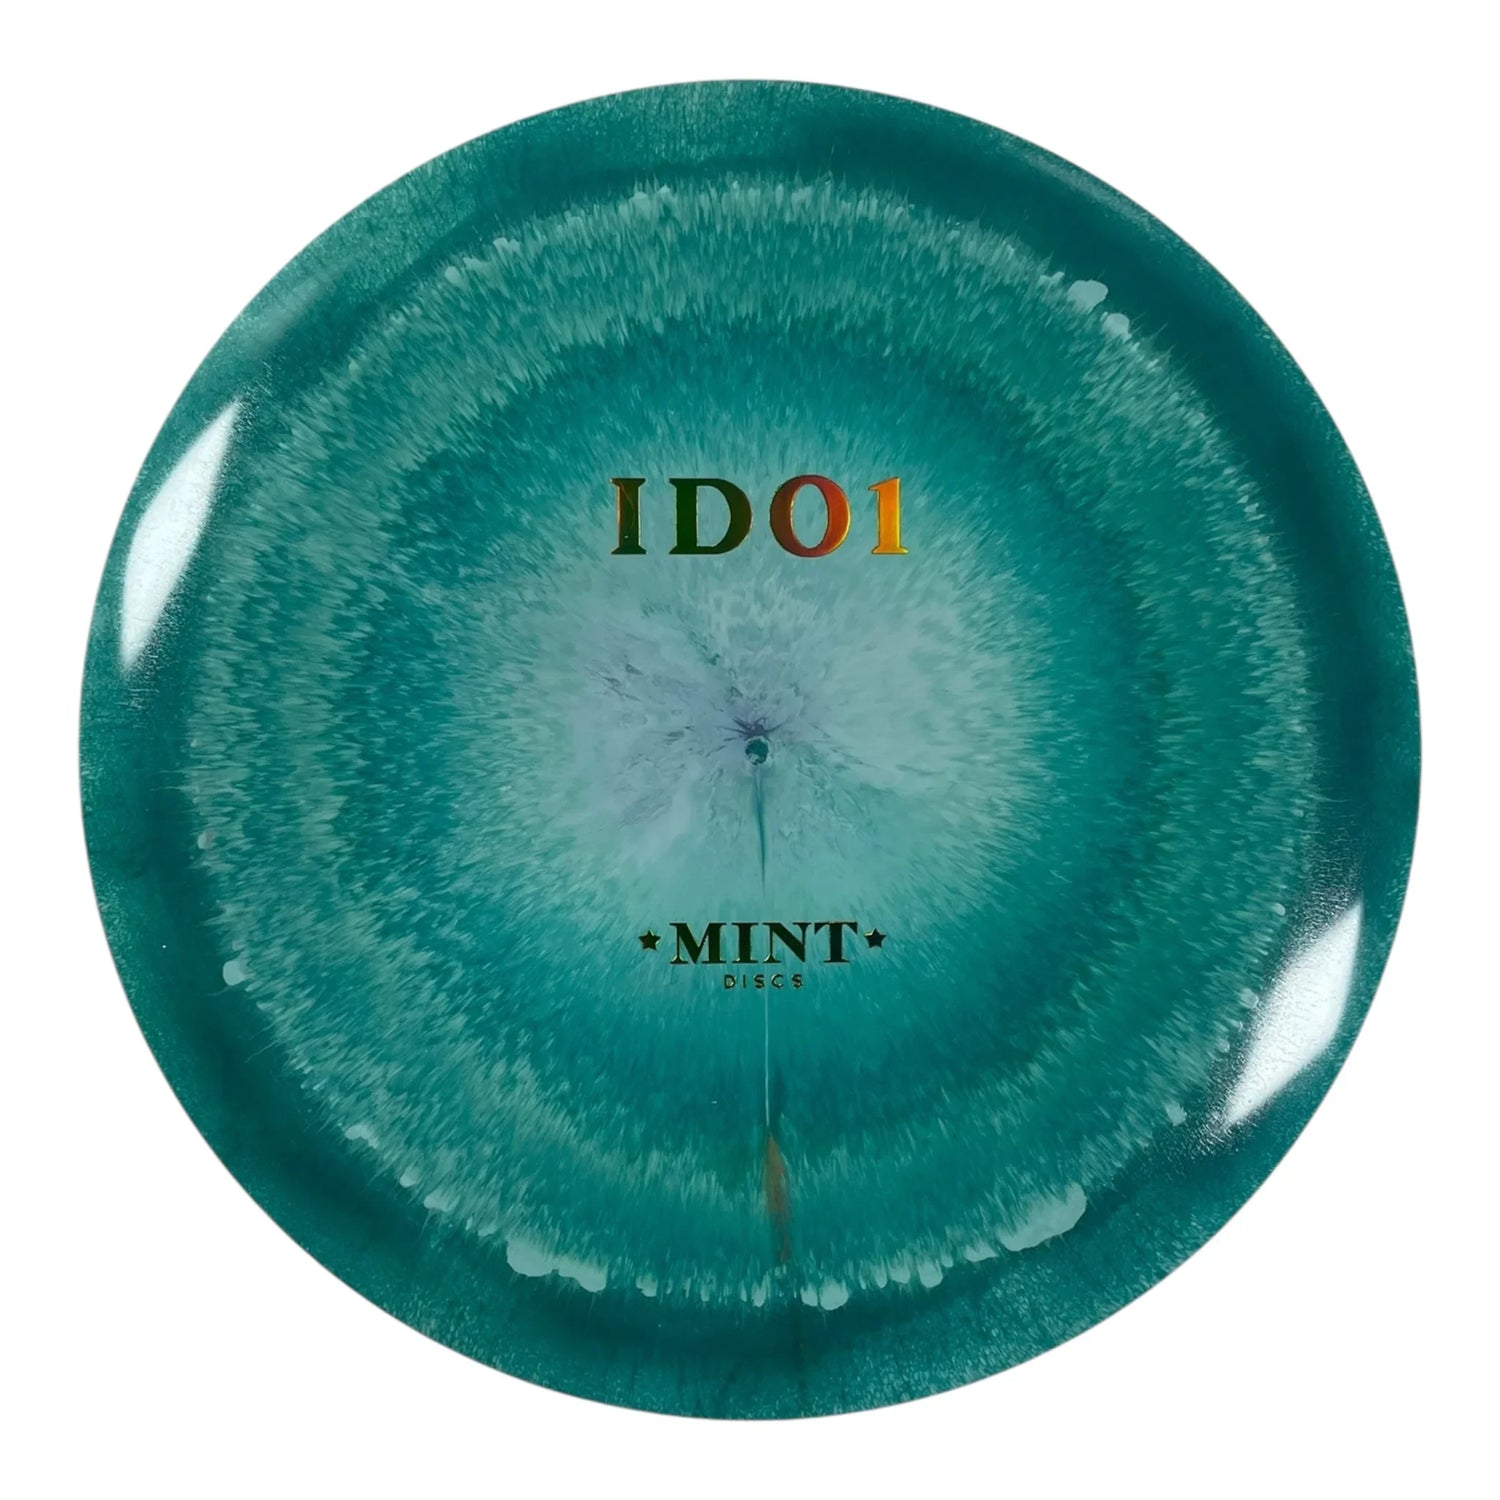
Mint Discs Idol | Elixir | Teal/Green Holo 164g (First Run) Disc Golf

Mint Discs
Idol | Elixir | Teal/Green Holo 164g (First Run)
- Regular price
-
$19.99 - Regular price
-
- Sale price
-
$19.99
Shipping calculated at checkout.
Convert your unwanted discs into store credit with our Perks Buyback Program
We include a pre-paid return label with your order
credit is added once your discs arrive and are inspected
Couldn't load pickup availability
|
Speed 13 |
Glide 5 |
|
Turn -1 |
Fade 2.5 |
PDGA Approved on Jul. 14, 2025 |
| Boasting flight numbers of 13 | 5 | -1 | 2.5, the Idol slots in as a stable-to-overstable bomber capable of handling torque without dumping early. Whether you're launching forehands into the wind or hammering full-power backhands, the Idol offers confident control with a consistent finish. |